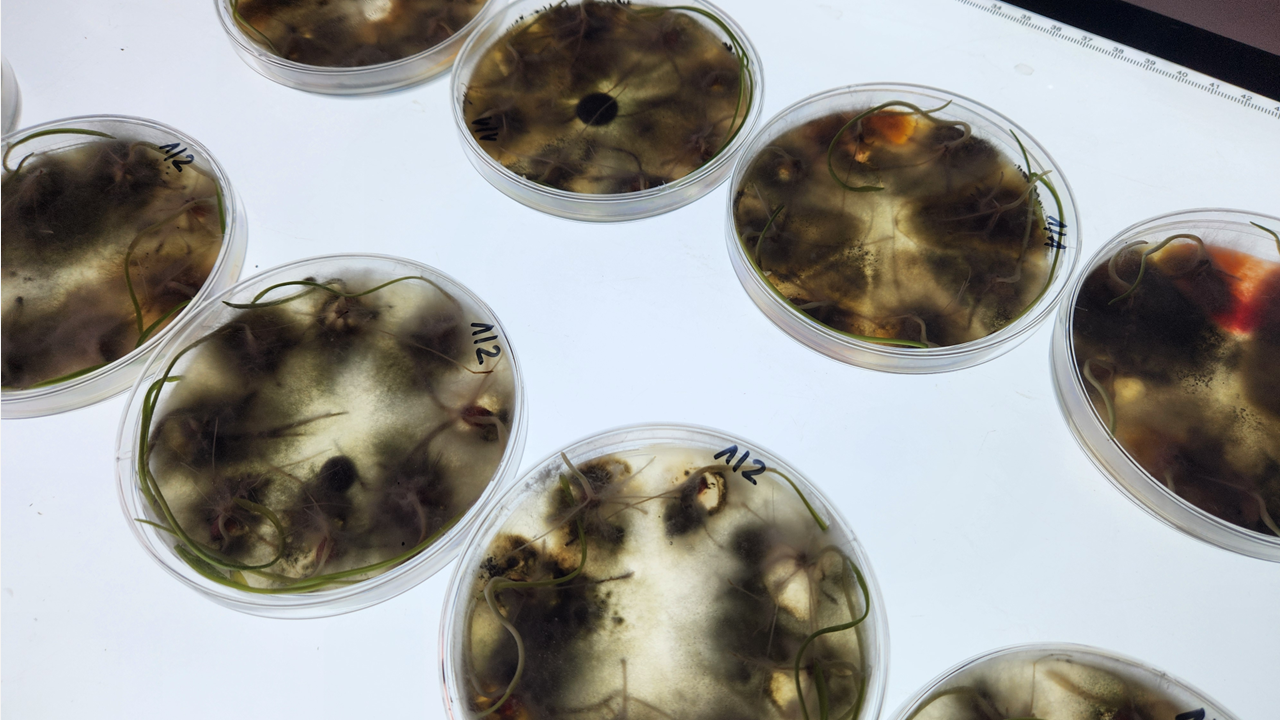
Miedź systemiczna w zabiegach czyszczących. Czy T0 będzie potrzebne tej wiosny?

Łotwa wycofuje się z Konwencji Stambulskiej
3 miesięcy temu
- Strona główna
- Zatrudnienie
- Łotwa wycofuje się z Konwencji Stambulskiej
Powiązane
Mniejszy zarząd Kino Polska TV. Odchodzi menedżer z Canal+
20 godzin temu
Koniec tanich rąk do pracy. Polska stawia na ekspertów AI
22 godzin temu
Polecane
Wielka rywalka Igi Świątek ogłosiła. To koniec
34 minut temu
Masz świnie? Od marca zmienią się zasady przemieszczania
50 minut temu